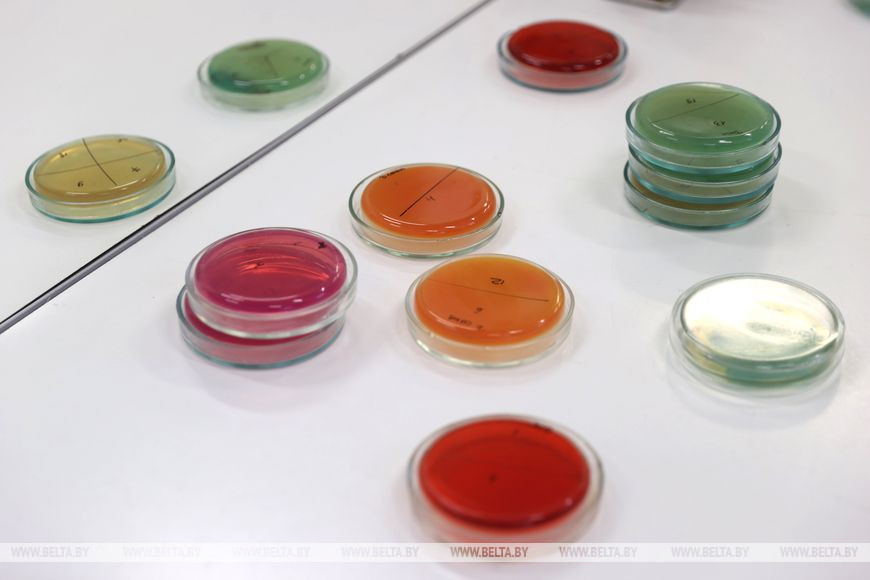

27 января, Минск /Корр. БЕЛТА/. Премьер-министр Роман Головченко посетил Научно-практический центр НАН Беларуси по продовольствию, где в преддверии Дня науки ученые показали свои наработки, передает корреспондент БЕЛТА.
НПЦ по продовольствию создан в 2006 году на основе БелНИИ пищевых продуктов, Института мясо-молочной промышленности и "Белтехнохлеба". Ученые НПЦ создают технологии производства продуктов питания для заводов. Они работают почти со всеми предприятиями - и государственными, и частными, и очень крупными, и мелкими. Работают и с фермерскими хозяйствами, например над технологией сушки сухофруктов. Роман Головченко ознакомился с деятельностью центра, его основными показателями развития, итогами работы за прошлый год, посетил лаборатории центра.
В настоящее время в стране реализуется пилотный проект Минобразования, который направлен на изучение вкусовых предпочтений школьников и совершенствование организации питания. Участвует в нем 21 белорусская школа: по три в каждой области и три - в Минске.

НПЦ НАН по продовольствию принимает активное участие в этом пилотном проекте. Премьер-министр изучил предлагаемые разработки центра для школьного питания. В частности, продукты, представленные в школьных буфетах, в рамках выполнения пилотного проекта, продукты для использования в школьных столовых.
Ученые стремятся, чтобы продукция была вкусной, но с низким содержанием сахара и соли, без острых специй. Например, разработаны аналоги кукурузных палочек из разных компонентов с уменьшенным количеством соли и сахара, а также батончики, низкобелковые снеки, картофель фри, изготовленный с уменьшенным содержанием масла, мультизлаковое печенье, обогащенное кальцием, и т.д. "Есть сегодня вопрос по глазированным сыркам. Мы также пытаемся доработать рецептуру, чтобы убрать повышенное содержание сахара и привести в соответствие к нормам, разработанным Минздравом. Мы работаем с производителями над рецептурами", - сказал генеральный директор НПЦ НАН по продовольствию Алексей Мелещеня.




Первый заместитель председателя концерна "Белгоспищепром" Татьяна Шедко отметила: "Основные наши новации - в кондитерской отрасли. Ключевое направление - производство продуктов здоровой линейки питания. Продукция содержит максимальное количество натуральных ингредиентов. Большая линейка продуктов производится без сахара, с уменьшением сахара. Мы стараемся произвести продукцию с богатой пищевой ценностью. В частности, обогащаем ее белками, полиненасыщенными жирными кислотами, пробиотиками, клетчаткой, питательными волокнами - то, что важно для пищеварения. Всю детскую линейку стараемся обогатить поливитаминным комплексом. Вся наша продукция может быть рекомендована целевым группам - для диетического, диабетического питания, для людей, ведущих активный образ жизни, а также страдающих непереносимостью лактозы, глютена и т.д.".
Пилотный проект стартовал 19 декабря 2022 года и завершится 30 апреля 2023 года.-0-
Фото Павла Орловского
- размещаются материалы рекламно-информационного характера.